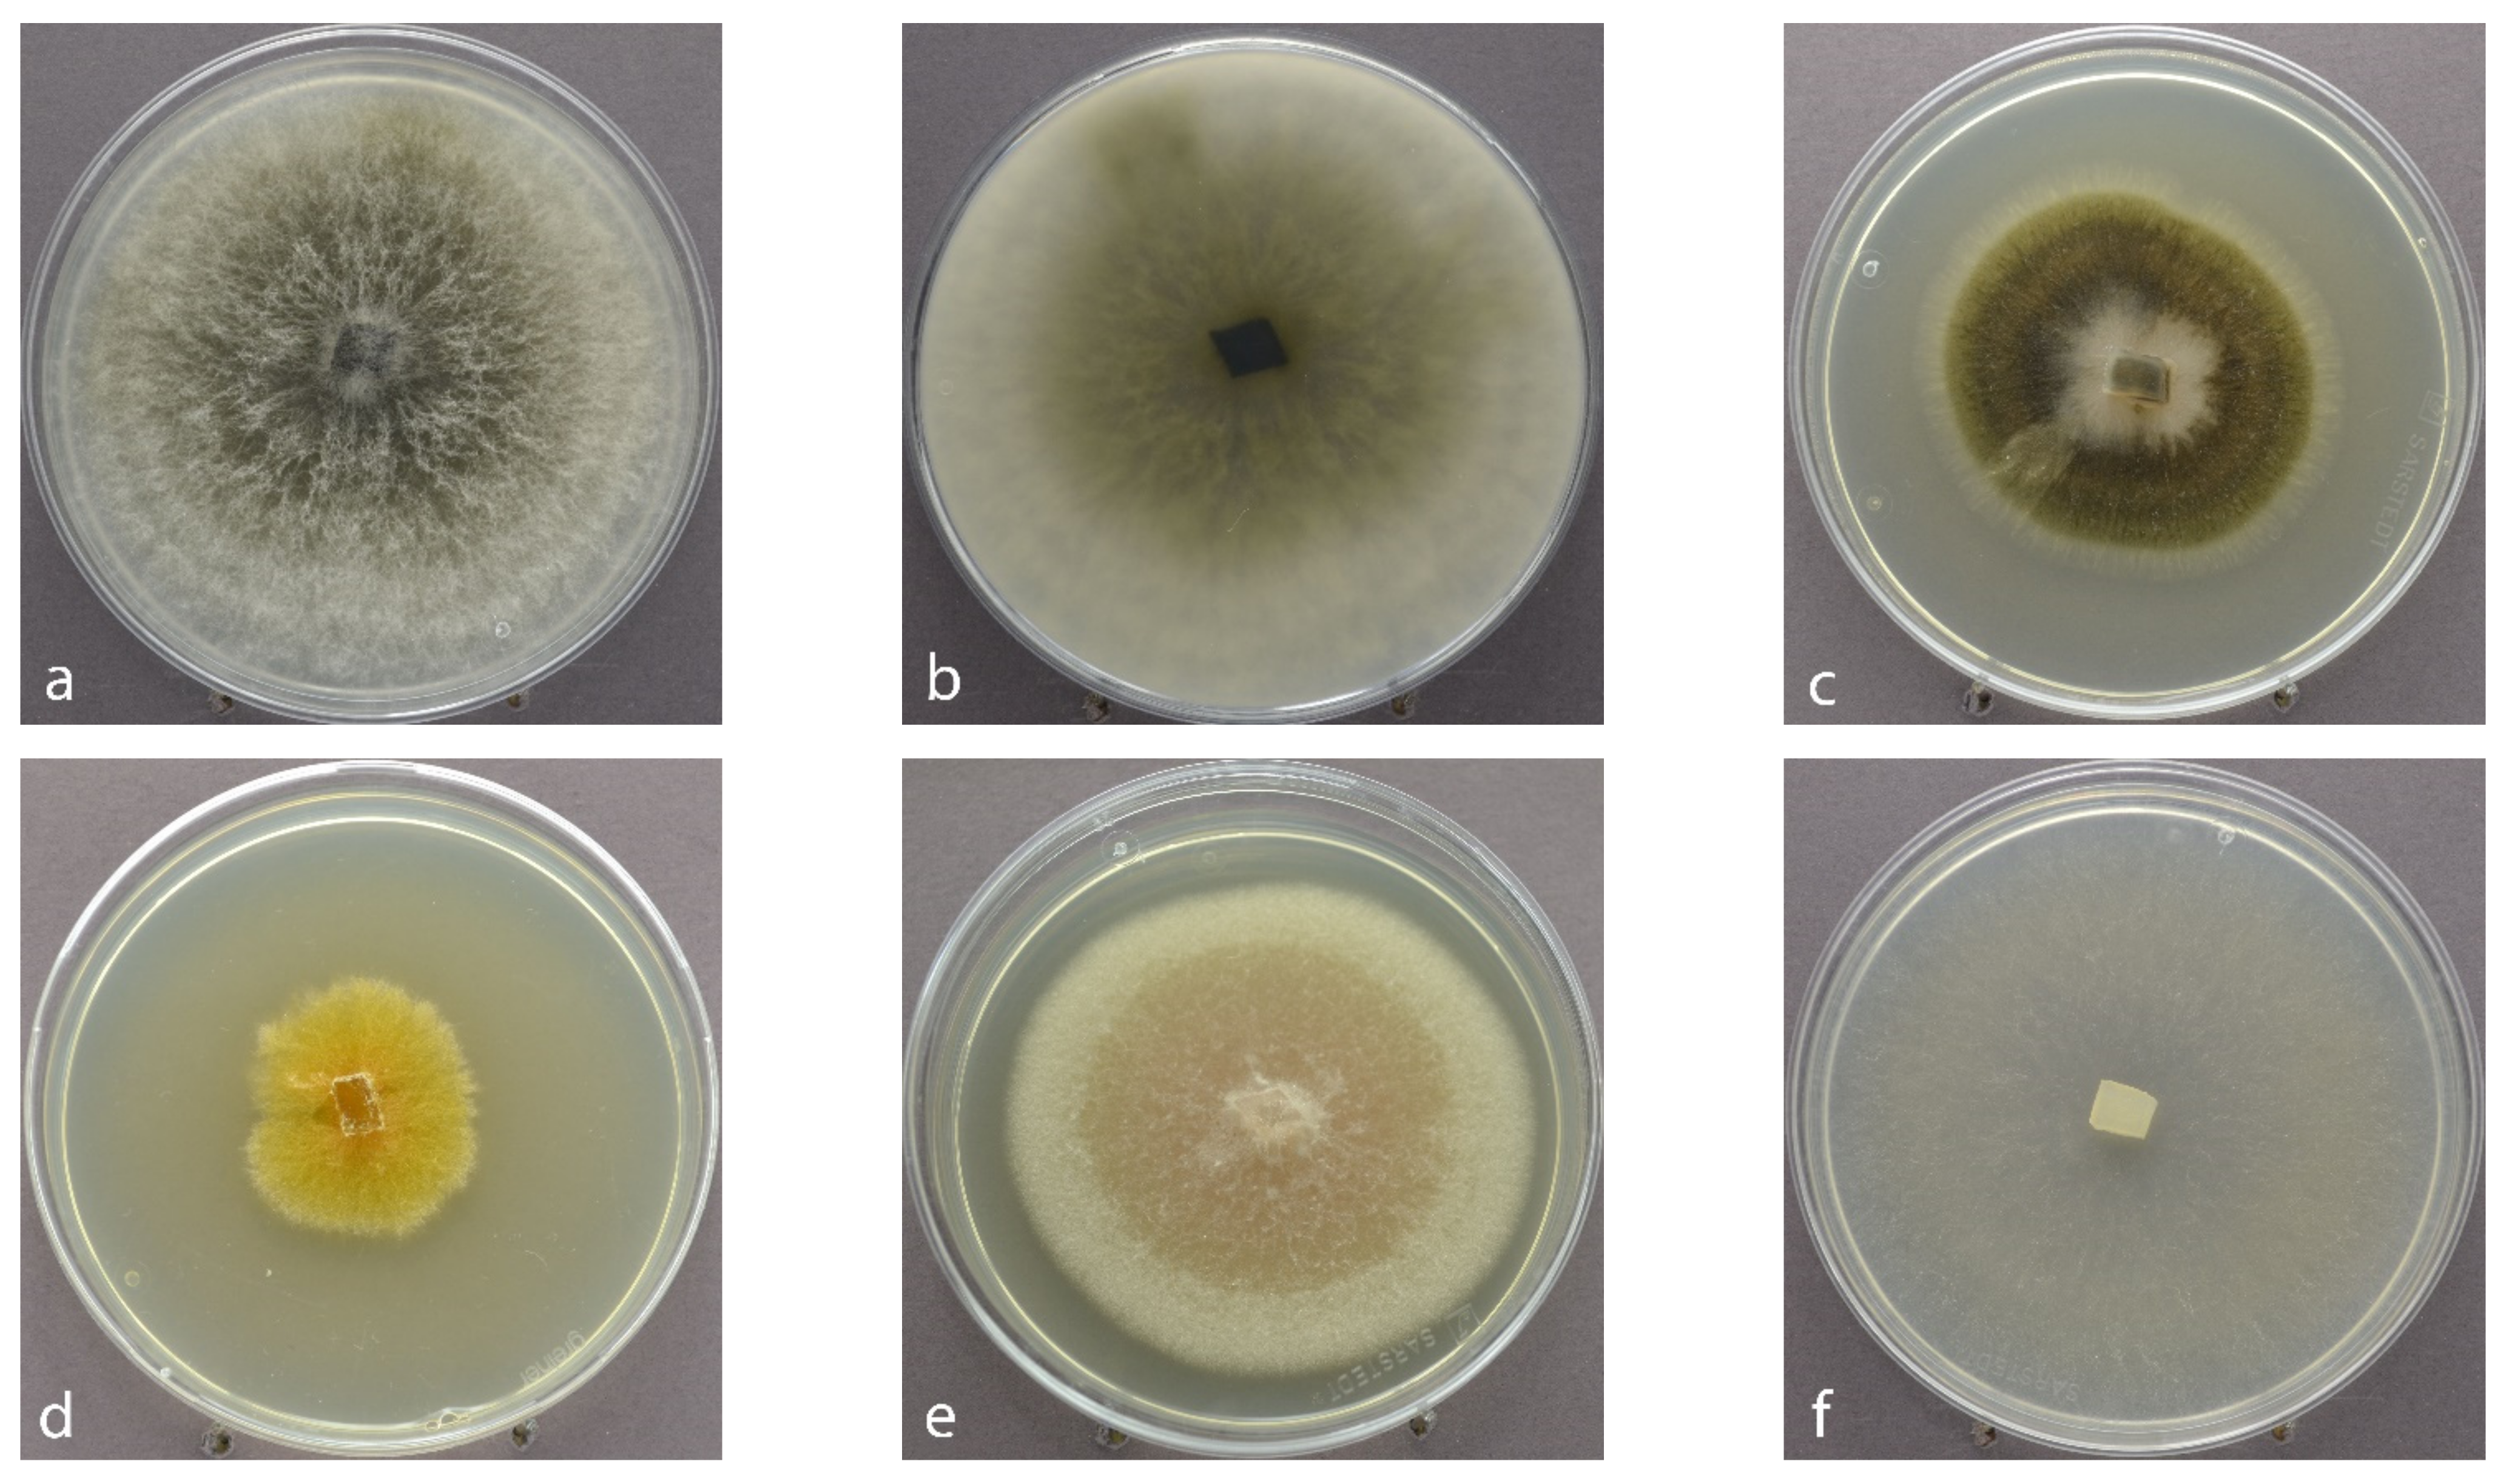
Jof 07 00607 g002
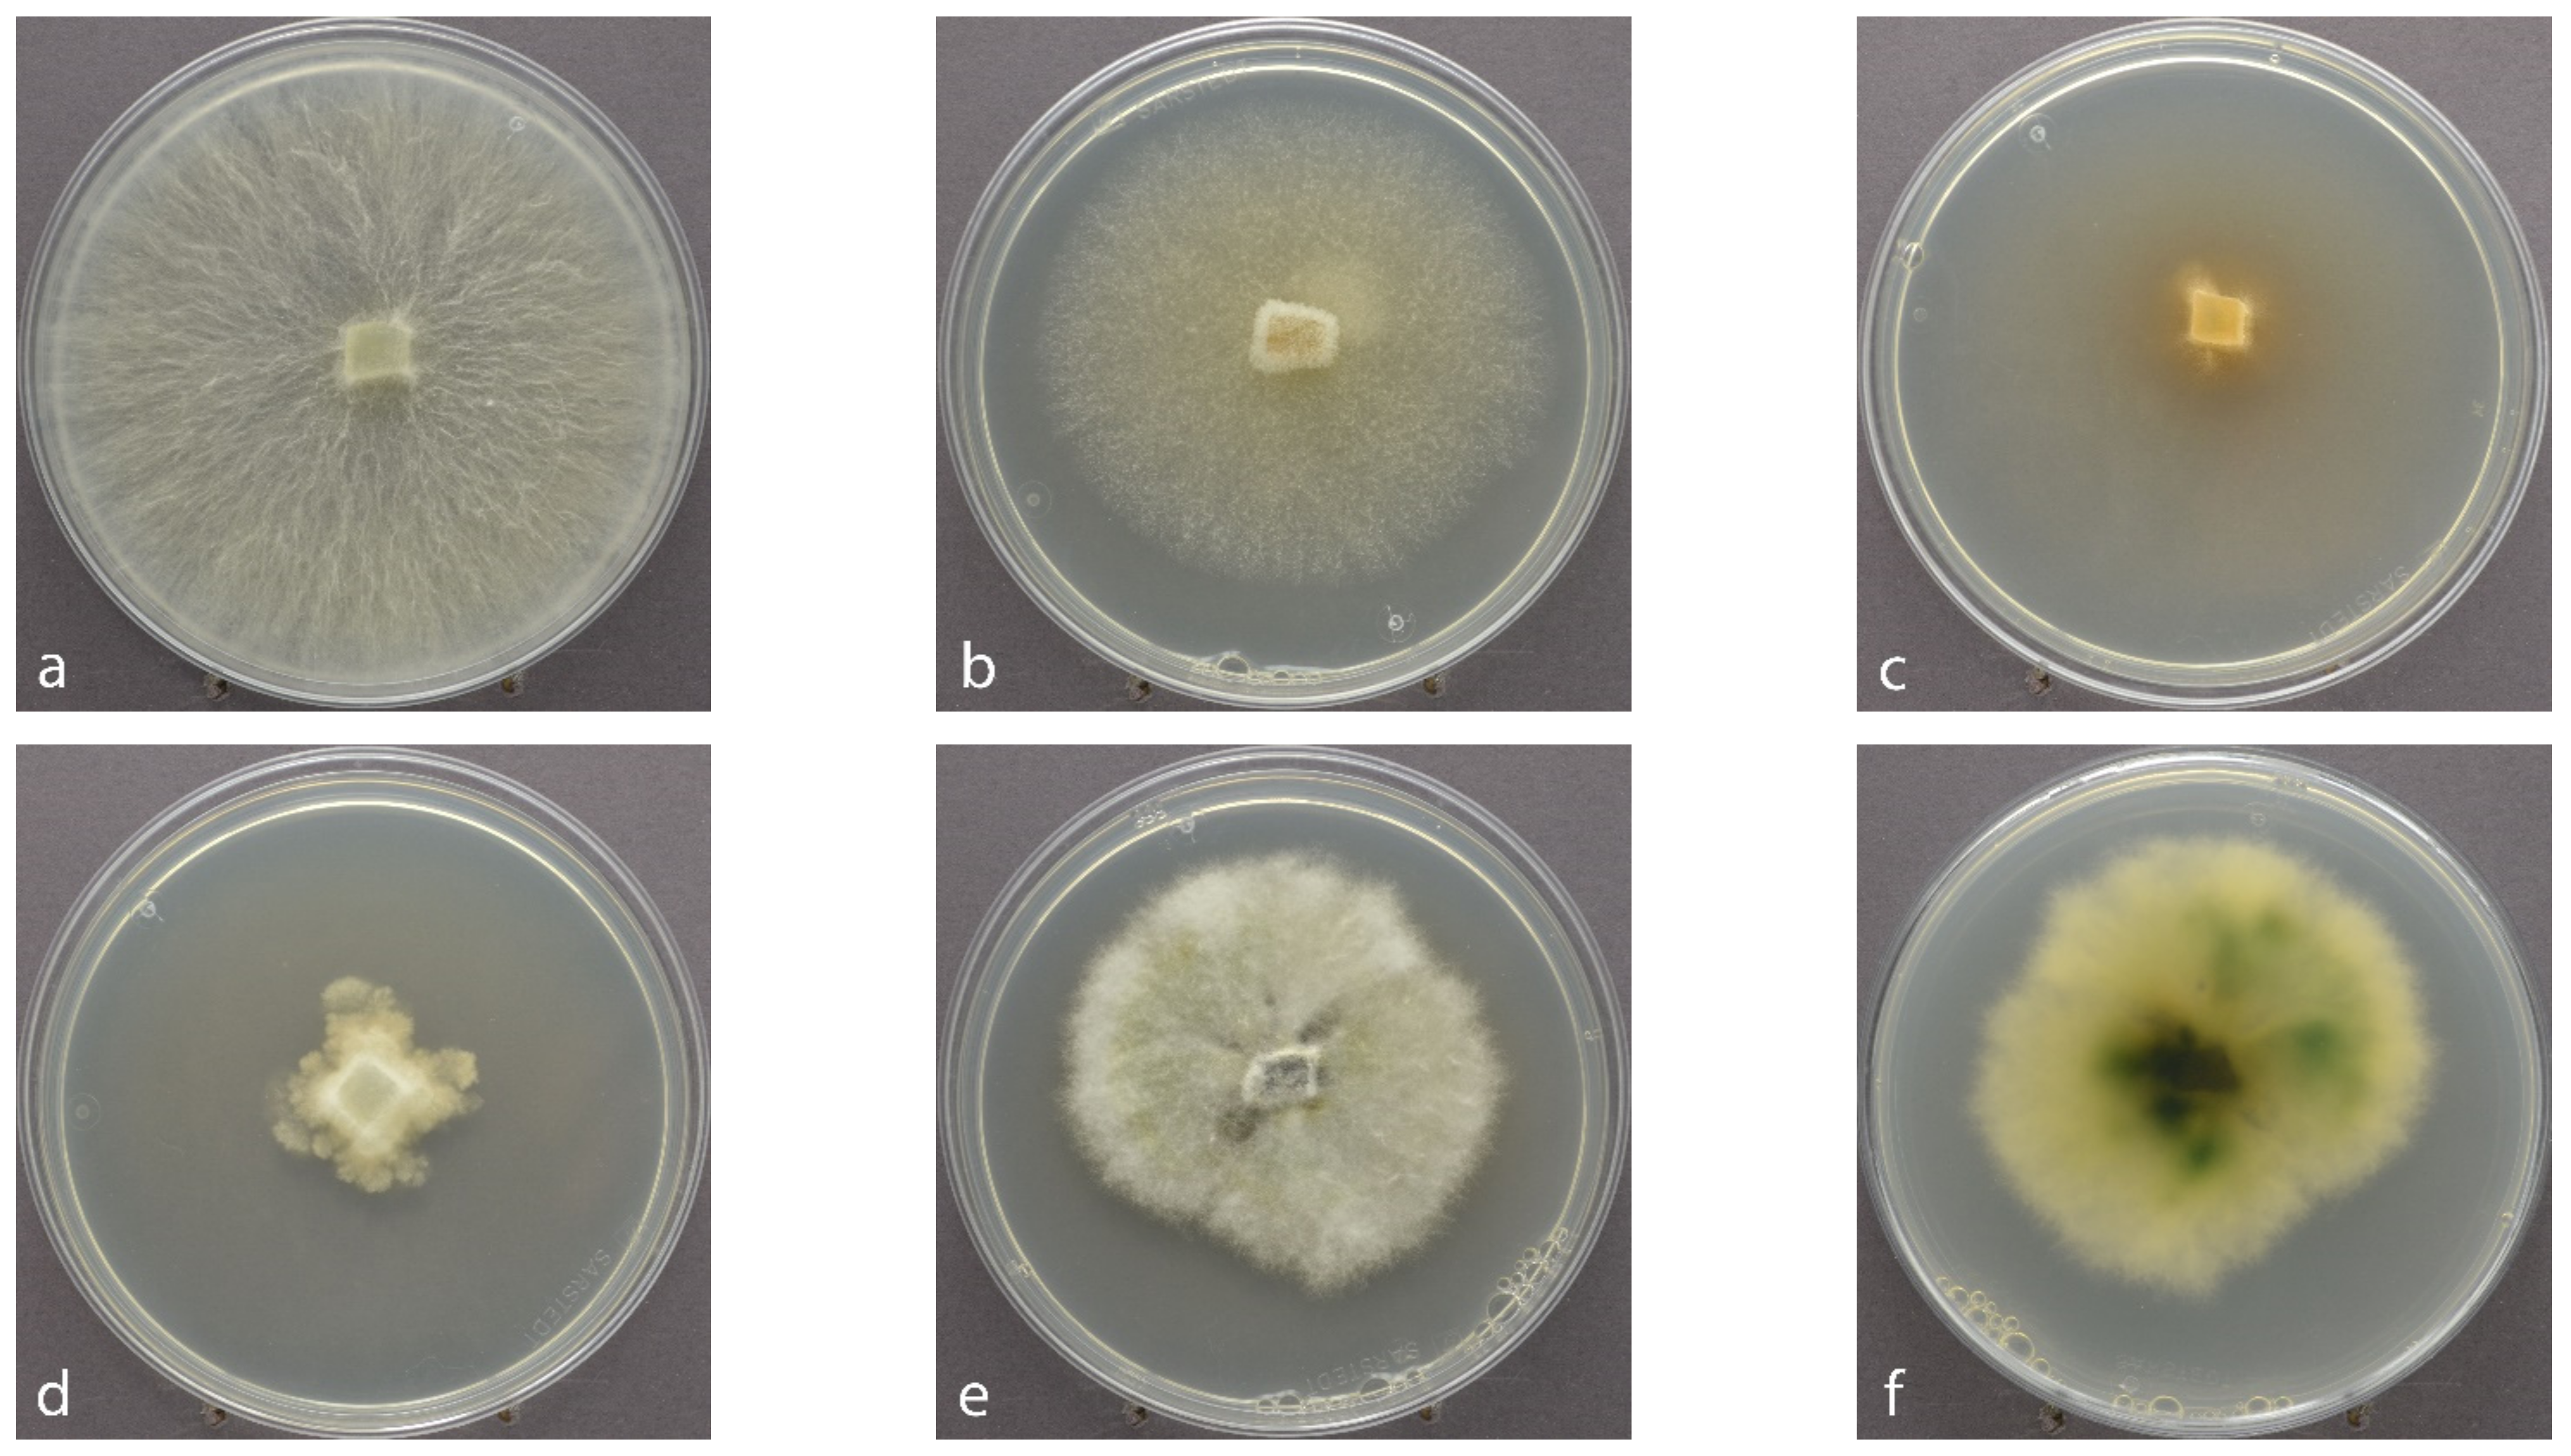
Jof 07 00607 g003

The Diplodia Tip Blight Pathogen Sphaeropsis sapinea Is the Most Common Fungus in Scots Pines’ Mycobiome, Irrespective of Health Status—A Case Study from Germany
Abstract
1. Introduction
2. Materials and Methods
2.1. Sampling Site
2.2. Culture-Based Isolation, Morphological and Molecular Identification
2.3. Fungal Metabarcoding and Data Analysis
3. Results
3.1. Fungal Isolates Retrieved by the Culture-Based versus the HTS Method
- 26% pathogenic on conifers (T. conorum-piceae, Bo. cinerea, Diaporthe sp., Rosellinia sp., S. sapinea, and Sy. polyspora).
- 26% typical saprotrophs (D. acicola, Pe. eucrita, Ph. lacerum, Ps. brabeji, Py. domesticum, and Th. fuckelii), except for Ps. Brabeji, which is usually found on needles or branches of pine).
- 17% typical hard wood colonizers with lifestyles from endophytic, parasitic to saprotrophs (B. mediterranea, B. nummularia, H. fragiforme, and N. serpens).
- 17%, typical generalists with various lifestyles but often saprobic (A. alternata, E. nigrum, M. olivacea, and S. fimicola).
- 9% coprophilous species, usually living on soil, dung, or plant debris (J. rotula and Preussia funiculata).
- The following wood-decay fungi were identified: B. mediterranea, B. nummularia, and H. fragiforme. Except for Diaporthe sp., P. funiculata, and Th. fuckelii, all other isolates of filamentous fungi were identified as typical endophytes of Scots pine twigs in the sense of Bußkamp et al. [20].
3.2. Disease Class
3.3. Sampling Time
3.4. Year of the Growth
3.5. Detection of S. sapinea
4. Discussion
4.1. Culture-Based Isolation and HTS Methods Complement Each Other
4.2. Yeasts—Common Epiphytes of Scots Pine Twigs
4.3. Mycobiome Differences between Sampling Factors
4.3.1. Disease Class
4.3.2. Sampling Time
4.3.3. Year of Growth
4.4. Detection of S. sapinea
5. Conclusions
Supplementary Materials
Author Contributions
Funding
Institutional Review Board Statement
Informed Consent Statement
Data Availability Statement
Acknowledgments
Conflicts of Interest
References
- Seidl, R.; Thom, D.; Kautz, M.; Martin-Benito, D.; Peltoniemi, M.; Vacchiano, G.; Wild, J.; Ascoli, D.; Petr, M.; Honkaniemi, J.; et al. Forest Disturbances under Climate Change. Nat. Clim. Chang. 2017, 7, 395–402. [Google Scholar] [CrossRef]
- Fries, E.M. Systema Mycologicum, Sistens Fungorum Ordines, Genera et Species; Gryphiswaldae; Sumtibus Ernesti Mauritti; Nabu Press: Charleston, SC, USA, 1823. [Google Scholar]
- De Wet, J.; Burgess, T.; Slippers, B.; Preisig, O.; Wingfield, B.D.; Wingfield, M.J. Multiple Gene Genealogies and Microsatellite Markers Reflect Relationships Between Morphotypes of Sphaeropsis sapinea and Distinguish a New Species of Diplodia. Mycol. Res. 2003, 107, 557–566. [Google Scholar] [CrossRef]
- Phillips, A.J.L.; Alves, A.; Abdollahzadeh, J.; Slippers, B.; Wingfield, M.J.; Groenewald, J.Z.; Crous, P.W. The Botryosphaeriaceae: Genera and Species Known from Culture. Stud. Mycol. 2013, 76, 51–167. [Google Scholar] [CrossRef] [PubMed]
- Smith, H.; Wingfield, M.; Crous, P.; Coutinho, T.A. Sphaeropsis sapinea and Botryosphaeria dothidea Endophytic in Pinus spp. and Eucalyptus spp. in South Africa. S. Afr. J. Bot. 1996, 62, 86–88. [Google Scholar] [CrossRef]
- Stanosz, G.R.; Smith, D.R.; Guthmiller, M.A.; Stanosz, J.C. Persistence of Sphaeropsis sapinea on or in Asymptomatic Shoots of Red and Jack Pines. Mycologia 1997, 89, 525–530. [Google Scholar] [CrossRef]
- Terhonen, E.; Babalola, J.; Kasanen, R.; Jalkanen, R.; Blumenstein, K. Sphaeropsis sapinea Found as Symptomless Endophyte in Finland. Silva Fenn. 2021, 55, 13. [Google Scholar] [CrossRef]
- Eldridge, K.G. Significance of Diplodia pinea in Plantations. Rev. Appl. Mycol. 1961, 41, 339. [Google Scholar]
- Swart, W.J.; Wingfield, M.J. Biology and Control of Sphaeropsis sapinea on Pinus Species in South Africa. Plant Dis. 1991, 75, 761–766. [Google Scholar] [CrossRef]
- Diekmann, M.; Sutherland, J.R.; Nowell, D.C.; Morales, F.J.; Allard, G. (Eds.) FAO/IPGRi Technical Guidelines for the Safty Movement of Germplasm; Bioversity International: Rome, Italy, 2002; Volume 21, ISBN 978-92-9043-525-9. [Google Scholar]
- Parnell, H.M. Shoot Blight of Pinus Radiata Don Caused by Diplodia Pinea (Desm.) Kickx; Forests Commission of Victoria: Beechworth, Australia, 1957. [Google Scholar]
- Chou, C.K.S. Crown Wilt of Pinus radiata Associated with Diplodia pinea Infection of Woody Stems. Eur. J. For. Pathol. 1987, 17, 398–411. [Google Scholar]
- Blumenstein, K.; Bußkamp, J.; Langer, G.J.; Schlößer, R.; Parra Rojas, N.M.; Terhonen, E. Sphaeropsis sapinea and Associated Endophytes in Scots Pine: Interactions and Effect on the Host Under Variable Water Content. Front. For. Glob. Chang. 2021, 4. [Google Scholar] [CrossRef]
- Stanosz, G.R.; Blodgett, J.T.; Smith, D.R.; Kruger, E.L. Water Stress and Sphaeropsis sapinea as a Latent Pathogen of Red Pine Seedlings. New Phytol. 2001, 149, 531–538. [Google Scholar] [CrossRef] [PubMed]
- Langer, G.J.; Bressem, U.; Habermann, M. Diplodia-Triebsterben der Kiefer und endophytischer Nachweis des Erregers Sphaeropsis sapinea. AFZ—Der Wald 2011, 11, 28–31. [Google Scholar]
- Ghelardini, L.; Pepori, A.L.; Luchi, N.; Capretti, P.; Santini, A. Drivers of Emerging Fungal Diseases of Forest Trees. For. Ecol. Manag. 2016, 381, 235–246. [Google Scholar] [CrossRef]
- Stanosz, G.R.; Smith, D.R.; Leisso, R. Diplodia Shoot Blight and Asymptomatic Persistence of Diplodia pinea on or in Stems of Jack Pine Nursery Seedlings. For. Pathol. 2007, 37, 145–154. [Google Scholar] [CrossRef]
- Paez, C.A.; Smith, J.A. First Report of Diplodia sapinea and Diplodia scrobiculata Causing an Outbreak of Tip Blight on Slash Pine in Florida. Plant Dis. 2018, 102, 1657. [Google Scholar] [CrossRef]
- Fabre, B.; Piou, D.; Desprez-Loustau, M.-L.; Marçais, B. Can the Emergence of Pine Diplodia Shoot Blight in France Be Explained by Changes in Pathogen Pressure Linked to Climate Change? Glob. Chang. Biol. 2011, 17, 3218–3227. [Google Scholar] [CrossRef]
- Bußkamp, J.; Langer, G.J.; Langer, E.J. Sphaeropsis sapinea and Fungal Endophyte Diversity in Twigs of Scots Pine (Pinus sylvestris) in Germany. Mycol. Prog. 2020, 19, 985–999. [Google Scholar] [CrossRef]
- Feci, E.; Battisti, A.; Capretti, P.; Tegli, S. An Association between the Fungus Sphaeropsis sapinea and the Cone Bug Gastrodes grossipes in Cones of Pinus nigra in Italy. For. Pathol. 2002, 32, 241–247. [Google Scholar] [CrossRef]
- Hernandez-Escribano, L.; Iturritxa, E.; Aragones, A.; Mesanza, N.; Berbegal, M.; Raposo, R.; Recuenco, M. Root Infection of Canker Pathogens, Fusarium circinatum and Diplodia sapinea, in Asymptomatic Trees in Pinus radiata and Pinus pinaster Plantations. Forests 2018, 9, 128. [Google Scholar] [CrossRef]
- Hanso, M.; Drenkhan, R. Diplodia pinea Is a New Pathogen on Austrian Pine (Pinus nigra) in Estonia. Plant Pathol. 2009, 58, 797. [Google Scholar] [CrossRef]
- Oliva, J.; Boberg, J.; Stenlid, J. First Report of Sphaeropsis sapinea on Scots Pine (Pinus sylvestris) and Austrian Pine (P. nigra) in Sweden. New Dis. Rep. 2013, 27, 23. [Google Scholar] [CrossRef]
- Brodde, L.; Adamson, K.; Julio Camarero, J.; Castaño, C.; Drenkhan, R.; Lehtijärvi, A.; Luchi, N.; Migliorini, D.; Sánchez-Miranda, Á.; Stenlid, J.; et al. Diplodia Tip Blight on Its Way to the North: Drivers of Disease Emergence in Northern Europe. Front. Plant Sci. 2019, 9, 1818. [Google Scholar] [CrossRef]
- Müller, M.M.; Hantula, J.; Wingfield, M.; Drenkhan, R. Diplodia sapinea Found on Scots Pine in Finland. For. Pathol. 2019, 49, e12483. [Google Scholar] [CrossRef]
- Cleary, M.; Oskay, F.; Doğmuş, H.T.; Lehtijärvi, A.; Woodward, S.; Vettraino, A.M. Cryptic Risks to Forest Biosecurity Associated with the Global Movement of Commercial Seed. Forests 2019, 10, 459. [Google Scholar] [CrossRef]
- Burgess, T.I.; Gordon, T.R.; Wingfield, M.J.; Wingfield, B.D. Geographic Isolation of Diplodia Scrobiculata and Its Association with Native Pinus radiata. Mycol. Res. 2004, 108, 1399–1406. [Google Scholar] [CrossRef]
- Vujanovic, V.; St-Arnaud, M.; Neumann, P.-J. Susceptibility of Cones and Seeds to Fungal Infection in a Pine (Pinus spp.) Collection. For. Pathol. 2000, 30, 305–320. [Google Scholar] [CrossRef]
- Iturritxa, E.; Ganley, R.J.; Raposo, R.; García-Serna, I.; Mesanza, N.; Kirkpatrick, S.C.; Gordon, T.R. Resistance Levels of Spanish Conifers against Fusarium circinatum and Diplodia pinea. For. Pathol. 2013, 43, 488–495. [Google Scholar] [CrossRef]
- Zlatković, M.; Keča, N.; Wingfield, M.J.; Jami, F.; Slippers, B. New and Unexpected Host Associations for Diplodia sapinea in the Western Balkans. For. Pathol. 2017, 47, e12328. [Google Scholar] [CrossRef]
- Langer, G.J.; Bußkamp, J.; Langer, E.J. Absterbeerscheinungen bei Rotbuche durch Trockenheit und Wärme. AFZ Der Wald 2020, 4, 4. [Google Scholar]
- Bußkamp, J. Schadenserhebung, Kartierung und Charakterisierung des Diplodia-Triebsterbens“ der Kiefer, Insbesondere des Endophytischen Vorkommens in den Klimasensiblen Räumen und Identifikation von Den in Kiefer (Pinus sylvestris) Vorkommenden Endophyten; Universität Kassel: Kassel, Germany, 2018. [Google Scholar]
- Peterson, G.W. Diplodia Blight of Pines. In Forest Insect & Disease Leaflet 161; USA Department of Agriculture, Forest Service, State & Private Forestry: Washington, DC, USA, 1981. [Google Scholar]
- Sinclair, W.A.; Lyon, H.H.; Johnson, W.T. Diseases of Trees and Shrubs—Second Edition; Cornell University Press: Ithaca, NY, USA, 1987. [Google Scholar]
- Terhonen, E.; Blumenstein, K.; Kovalchuk, A.; Asiegbu, F.O. Forest Tree Microbiomes and Associated Fungal Endophytes: Functional Roles and Impact on Forest Health. Forests 2019, 10, 42. [Google Scholar] [CrossRef]
- Witzell, J.; Martín, J.A. Endophytes and forest health. In Endophytes of Forest Trees: Biology and Applications; Pirttilä, A.M., Frank, A.C., Eds.; Forestry Sciences; Springer International Publishing: Basel, Switzerland, 2018; pp. 261–282. ISBN 978-3-319-89833-9. [Google Scholar]
- Witzell, J.; Martín, J.A.; Blumenstein, K. Ecological aspects of endophyte-based biocontrol of forest diseases. In Advances in Endophytic Research; Verma, V.C., Gange, A.C., Eds.; Springer: New Delhi, India, 2014; pp. 321–333. ISBN 978-81-322-1575-2. [Google Scholar]
- Oliva, J.; Ridley, M.; Redondo, M.A.; Caballol, M. Competitive Exclusion amongst Endophytes Determines Shoot Blight Severity on Pine. Funct. Ecol. 2021, 35, 239–254. [Google Scholar] [CrossRef]
- Saikkonen, K.; Faeth, S.H.; Helander, M.; Sullivan, T.J. Fungal Endophytes: A Continuum of Interactions with Host Plants. Ann. Rev. Ecol. Syst. 1998, 29, 319–343. [Google Scholar] [CrossRef]
- Blumenstein, K.; Albrectsen, B.R.; Martín, J.A.; Hultberg, M.; Sieber, T.N.; Helander, M.; Witzell, J. Nutritional Niche Overlap Potentiates the Use of Endophytes in Biocontrol of a Tree Disease. BioControl 2015, 60, 655–667. [Google Scholar] [CrossRef]
- Miller, J.D.; Sumarah, M.W.; Adams, G.W. Effect of a Rugulosin-Producing Endophyte in Picea glauca on Choristoneura fumiferana. J. Chem. Ecol. 2008, 34, 362–368. [Google Scholar] [CrossRef]
- Ganley, R.J.; Sniezko, R.A.; Newcombe, G. Endophyte-Mediated Resistance against White Pine Blister Rust in Pinus monticola. For. Ecol. Manag. 2008, 255, 2751–2760. [Google Scholar] [CrossRef]
- Mejía, L.C.; Rojas, E.I.; Maynard, Z.; Bael, S.V.; Arnold, A.E.; Hebbar, P.; Samuels, G.J.; Robbins, N.; Herre, E.A. Endophytic Fungi as Biocontrol Agents of Theobroma cacao Pathogens. Biol. Control 2008, 46, 4–14. [Google Scholar] [CrossRef]
- Sumarah, M.W.; Kesting, J.R.; Sørensen, D.; Miller, J.D. Antifungal Metabolites from Fungal Endophytes of Pinus strobus. Phytochemistry 2011, 72, 1833–1837. [Google Scholar] [CrossRef]
- Tellenbach, C.; Sieber, T.N. Do Colonization by Dark Septate Endophytes and Elevated Temperature Affect Pathogenicity of Oomycetes? FEMS Microbiol. Ecol. 2012, 82, 157–168. [Google Scholar] [CrossRef]
- Martín, J.A.; Witzell, J.; Blumenstein, K.; Rozpedowska, E.; Helander, M.; Sieber, T.N.; Gil, L. Resistance to Dutch Elm Disease Reduces Presence of Xylem Endophytic Fungi in Elms (Ulmus spp.). PLoS ONE 2013, 8, e56987. [Google Scholar] [CrossRef] [PubMed]
- Richardson, S.N.; Walker, A.K.; Nsiama, T.K.; McFarlane, J.; Sumarah, M.W.; Ibrahim, A.; Miller, J.D. Griseofulvin-Producing Xylaria Endophytes of Pinus strobus and Vaccinium angustifolium: Evidence for a Conifer-Understory Species Endophyte Ecology. Fungal Ecol. 2014, 11, 107–113. [Google Scholar] [CrossRef]
- Romeralo, C.; Santamaria, O.; Pando, V.; Diez, J.J. Fungal Endophytes Reduce Necrosis Length Produced by Gremmeniella abietina in Pinus halepensis Seedlings. Biol. Control 2015, 80, 30–39. [Google Scholar] [CrossRef]
- Postma, J.; Goossen-Van De Geijn, H. Twenty-Four Years of Dutch Trig® Application to Control Dutch Elm Disease. BioControl 2016, 61, 305–312. [Google Scholar] [CrossRef]
- Terhonen, E.; Sipari, N.; Asiegbu, F.O. Inhibition of Phytopathogens by Fungal Root Endophytes of Norway Spruce. Biol. Control 2016, 99, 53–63. [Google Scholar] [CrossRef]
- Doty, S.L. Endophytic Yeasts: Biology and Applications. In Symbiotic Endophytes; Aroca, R., Ed.; Soil Biology; Springer: Berlin/Heidelberg, Germany, 2013; pp. 335–343. ISBN 978-3-642-39317-4. [Google Scholar]
- Kemler, M.; Witfeld, F.; Begerow, D.; Yurkov, A. Phylloplane Yeasts in Temperate Climates. In Yeasts in Natural Ecosystems: Diversity; Buzzini, P., Lachance, M.-A., Yurkov, A., Eds.; Springer International Publishing: Basel, Switzerland, 2017; pp. 171–197. ISBN 978-3-319-62683-3. [Google Scholar]
- Terhonen, E.; Marco, T.; Sun, H.; Jalkanen, R.; Kasanen, R.; Vuorinen, M.; Asiegbu, F. The Effect of Latitude, Season and Needle-Age on the Mycota of Scots Pine (Pinus sylvestris) in Finland. Silva Fenn. 2011, 45. [Google Scholar] [CrossRef]
- Nilsson, R.H.; Anslan, S.; Bahram, M.; Wurzbacher, C.; Baldrian, P.; Tedersoo, L. Mycobiome Diversity: High-Throughput Sequencing and Identification of Fungi. Nat. Rev. Microbiol. 2019, 17, 95–109. [Google Scholar] [CrossRef]
- Lindahl, B.D.; Nilsson, R.H.; Tedersoo, L.; Abarenkov, K.; Carlsen, T.; Kjøller, R.; Kõljalg, U.; Pennanen, T.; Rosendahl, S.; Stenlid, J.; et al. Fungal Community Analysis by High-Throughput Sequencing of Amplified Markers—A User’s Guide. New Phytol. 2013, 199, 288–299. [Google Scholar] [CrossRef]
- Tedersoo, L.; Anslan, S.; Bahram, M.; Põlme, S.; Riit, T.; Liiv, I.; Kõljalg, U.; Kisand, V.; Nilsson, H.; Hildebrand, F.; et al. Shotgun Metagenomes and Multiple Primer Pair-Barcode Combinations of Amplicons Reveal Biases in Metabarcoding Analyses of Fungi. MycoKeys 2015, 10, 1–43. [Google Scholar] [CrossRef]
- Tedersoo, L.; Bahram, M.; Puusepp, R.; Nilsson, R.H.; James, T.Y. Novel Soil-Inhabiting Clades Fill Gaps in the Fungal Tree of Life. Microbiome 2017, 5, 42. [Google Scholar] [CrossRef]
- Flowers, J.; Hartman, J.R.; Vaillancourt, L.J. Histology of Diplodia pinea in Diseased and Latently Infected Pinus nigra Shoots. For. Pathol. 2006, 36, 447–459. [Google Scholar] [CrossRef]
- Langer, G.J. Die Gattung Botryobasidium DONK (Corticiaceae, -Basidiomycetes); Bibliotheca Mycologica, J. Cramer: Berlin, Stuttgart, 1994; Volume 158. [Google Scholar]
- Lee, I.-S.; Langer, E. New Records of Hyphodontia Species from Taiwan. Nova Hedwig. 2012, 94, 239–244. [Google Scholar] [CrossRef]
- Oertel, B. Bibliographische Recherchen in Der Mykologie. Ein Leitfaden Für Leser Im Deutschsprachigen Raum Und Darüber Hinaus. Z. Mykol. 2003, 69, 3–42. [Google Scholar]
- Butin, H. Krankheiten Der Wald- Und Parkbäume—Diagnose, Biologie, Bekämpfung; Eugen Ulmer: Stuttgart, Germany, 2011. [Google Scholar]
- Guba, E. Monograph of Monochaetia and Pestalotia; Harvard University Press: Cambridge, MA, USA, 1961. [Google Scholar]
- Breitenbach, J.; Kränzlin, F. Pilze der Schweiz. Band 1: Ascomyceten; Verlag Mykologia: Luzern, Switzerland, 1984. [Google Scholar]
- Von Arx, J. The Genera of Fungi Sporulating in Pure Culture, 3rd ed.; J. Cramer: Vaduz, Liechtenstein, 1981. [Google Scholar]
- Booth, C. The Genus Fusarium; Commonwealth Mycological Institute: Richmond, UK, 1971. [Google Scholar]
- Domsch, K.; Gams, W.; Anderson, T. Compendium of Soil Fungi; Reprint of Edition 1980; Atlantic Books: Eching, Germany, 1980. [Google Scholar]
- Gerlach, W.; Nirenberg, H. The Genus Fusarium—A Pictorial Atlas; Mitteilungen aus der Biologischen Bundesanstalt für Land- und Forstwirtschaft; Biologischen Bundesanstalt für Land- und Forstwirtschaft: Berlin, Germany, 1982. [Google Scholar]
- Ju, Y.; Rogers, J.; Martín, F.; Granmo, A. The Genus Biscogniauxia. Mycotaxon 1998, 66, 1–98. [Google Scholar]
- Verkley, G.J.M. A Monograph of the Genus Pezicula and Its Anamorphs. Stud. Mycol. 1999, 44, 1–180. [Google Scholar]
- Samson, R.; Houbraken, J.; Thrane, U.; Frisvad, J.; Andersen, B. Food and Indoor Fungi; CBS-KNAW Fungal Biodiversity Centre: Utrecht, The Netherlands, 2010. [Google Scholar]
- Keriö, S.; Terhonen, E.; LeBoldus, J. Safe DNA-Extraction Protocol Suitable for Studying Tree-Fungus Interactions. Bio-Protocol 2020, 10. [Google Scholar] [CrossRef]
- White, T.J.; Bruns, T.; Lee, S.; Taylor, J. Amplification and Direct Sequencing of Fungal Ribosomal RNA Genes for Phylogenetics. PCR Protoc. A Guide Methods Appl. 1990, 18, 315–322. [Google Scholar]
- Gardes, M.; Bruns, T.D. ITS Primers with Enhanced Specificity for Basidiomycetes-application to the Identification of Mycorrhizae and Rusts. Mol. Ecol. 1993, 2, 113–118. [Google Scholar] [CrossRef] [PubMed]
- Bengtsson-Palme, J.; Ryberg, M.; Hartmann, M.; Branco, S.; Wang, Z.; Godhe, A.; Wit, P.D.; Sánchez-García, M.; Ebersberger, I.; de Sousa, F.; et al. Improved Software Detection and Extraction of ITS1 and ITS2 from Ribosomal ITS Sequences of Fungi and Other Eukaryotes for Analysis of Environmental Sequencing Data. Methods Ecol. Evol. 2013, 4, 914–919. [Google Scholar] [CrossRef]
- Zhang, Z.; Schwartz, S.; Wagner, L.; Miller, W. A Greedy Algorithm for Aligning DNA Sequences. J. Comput. Biol. 2000, 7, 203–214. [Google Scholar] [CrossRef]
- Sayers, E.W.; Barrett, T.; Benson, D.A.; Bolton, E.; Bryant, S.H.; Canese, K.; Chetvernin, V.; Church, D.M.; DiCuccio, M.; Federhen, S.; et al. Database Resources of the National Center for Biotechnology Information. Nucleic Acids Res. 2011, 39, D38–D51. [Google Scholar] [CrossRef]
- Illumina 16S Metagenomics Sequencing Workflow. Available online: https://www.illumina.com/ (accessed on 4 April 2020).
- Babraham Bioinformatics—FastQC A Quality Control Tool for High Throughput Sequence Data. Available online: http://www.bioinformatics.babraham.ac.uk/projects/fastqc/ (accessed on 23 May 2020).
- Martin, M. Cutadapt Removes Adapter Sequences from High-Throughput Sequencing Reads. EMBnet J. 2011, 17, 3. [Google Scholar] [CrossRef]
- Love, M.I.; Huber, W.; Anders, S. Moderated Estimation of Fold Change and Dispersion for RNA-Seq Data with DESeq2. Genome Biol. 2014, 15, 550. [Google Scholar] [CrossRef]
- R Core Team. R: A Language and Environment for Statistical Computing; R Foundation for Statistical Computing: Vienna, Austria, 2020. Available online: https://www.r-project.org/ (accessed on 23 May 2020).
- Shannon, C.E. A Mathematical Theory of Communication. Bell Syst. Tech. J. 1948, 27, 379–423. [Google Scholar] [CrossRef]
- Simpson, E.H. Measurement of Diversity. Nature 1949, 163, 688. [Google Scholar] [CrossRef]
- Oksanen, J.; Blanchet, F.G.; Friendly, M.; Kindt, R.; Legendre, P.; McGlinn, D.; Minchin, P.R.; O’Hara, R.B.; Simpson, G.L.; Solymos, P. Vegan: Community Ecology Package; R Package Version 2.4-1; R Foundation for Statistical Computing: Vienna, Austria, 2016. [Google Scholar]
- Cáceres, M.D.; Legendre, P.; Moretti, M. Improving Indicator Species Analysis by Combining Groups of Sites. Oikos 2010, 119, 1674–1684. [Google Scholar] [CrossRef]
- Nguyen, N.H.; Song, Z.; Bates, S.T.; Branco, S.; Tedersoo, L.; Menke, J.; Schilling, J.S.; Kennedy, P.G. FUNGuild: An Open Annotation Tool for Parsing Fungal Community Datasets by Ecological Guild. Fungal Ecol. 2016, 20, 241–248. [Google Scholar] [CrossRef]
- Camatti-Sartori, V.; Da Silva-Ribeiro, R.T.; Valdebenito-Sanhueza, R.M.; Pagnocca, F.C.; Echeverrigaray, S.; Azevedo, J.L. Endophytic Yeasts and Filamentous Fungi Associated with Southern Brazilian Apple (Malus domestica) Orchards Subjected to Conventional, Integrated or Organic Cultivation. J. Basic Microbiol. 2005, 45, 397–402. [Google Scholar] [CrossRef] [PubMed]
- Bura, R.; Vajzovic, A.; Doty, S.L. Novel Endophytic Yeast Rhodotorula mucilaginosa Strain PTD3 I: Production of Xylitol and Ethanol. J. Ind. Microbiol. Biotechnol. 2012, 39, 1003–1011. [Google Scholar] [CrossRef] [PubMed]
- Brewer, M.; Turner, A.; Brannen, P.; Cline, W.; Richardson, B. Exobasidium maculosum, a New Species Causing Leaf and Fruit Spots on Blueberry in the Southeastern USA and Its Relationship with Other Exobasidium spp. Parasitic to Blueberry and Cranberry. Mycologia 2014, 106. [Google Scholar] [CrossRef]
- Tedersoo, L.; Bahram, M.; Põlme, S.; Kõljalg, U.; Yorou, N.S.; Wijesundera, R.; Ruiz, L.V.; Vasco-Palacios, A.M.; Thu, P.Q.; Suija, A.; et al. Global Diversity and Geography of Soil Fungi. Science 2014, 346. [Google Scholar] [CrossRef]
- Solheim, H.; Torp, T.; Hietala, A. Characterization of the Ascomycetes Therrya fuckelii and T. pini Fruiting on Scots Pine Branches in Nordic Countries. Mycol. Prog. 2013, 12, 37–44. [Google Scholar] [CrossRef]
- Minter, D. Therrya pini—IMI Descriptions of Fungi and Bacteria. Mycopathologia 1996, 136, 175–177. [Google Scholar] [CrossRef] [PubMed]
- Sanz-Ros, A.V.; Müller, M.M.; San Martín, R.; Diez, J.J. Fungal Endophytic Communities on Twigs of Fast and Slow Growing Scots Pine (Pinus sylvestris L.) in Northern Spain. Fungal Biol. 2015, 119, 870–883. [Google Scholar] [CrossRef] [PubMed]
- Pilze der Schweiz. Beitrag zur Kenntnis der Pilzflora der Schweiz. Band I: Ascomyceten. von Breitenbach, J. & F.Kränzin. Antiquariaat A. Kok & Zn. B.V. Available online: https://www.zvab.com/Pilze-Schweiz-Beitrag-Kenntnis-Pilzflora-Schweiz/30492444247/bd (accessed on 11 May 2020).
- Petrini, O.; Fisher, P.J. A Comparative Study of Fungal Endophytes in Xylem and Whole Stem of Pinus sylvestris and Fagus sylvatica. Trans. Br. Mycol. Soc. 1988, 91, 233–238. [Google Scholar] [CrossRef]
- Kowalski, T.; Kehr, R. Endophytic Fungal Colonization of Branch Bases in Several Forest Tree Species. Sydowia 1992, 44, 137–168. [Google Scholar]
- Peršoh, D.; Melcher, M.; Flessa, F.; Rambold, G. First Fungal Community Analyses of Endophytic Ascomycetes Associated with Viscum album ssp. austriacum and Its Host Pinus sylvestris. Fungal Biol. 2010, 114, 585–596. [Google Scholar] [CrossRef]
- Martínez-Álvarez, P.; Rodríguez-Ceinós, S.; Martín-García, J.; Diez, J.J. Monitoring Endophyte Populations in Pine Plantations and Native Oak Forests in Northern Spain. For. Syst. 2012, 21, 373. [Google Scholar] [CrossRef]
- Chastagner, G.A.; Staley, J.M.; Riley, K.L. Current Season Needle Necrosis: A Needle Disorder of Unknown Etiology on Noble and Grand Fir Christmas Trees in the Pacific Northwest; General Technical Report WO; USA Department of Agriculture, Forest Service: Washington, DC, USA, 1990.
- Chastagner, G.A.; Riley, K. Diseases that limit the production of noble fir Christmas trees in the Pacific Northwest. In Improvements in Christmas Tree and Greenery Quality; Danish Center for Forest, Landscape and Planning: Copenhagen, Denmark, 2000; pp. 13–21. [Google Scholar]
- Talgø, V.; Chastagner, G.; Thomsen, I.M.; Cech, T.; Riley, K.; Lange, K.; Klemsdal, S.S.; Stensvand, A. Sydowia polyspora Associated with Current Season Needle Necrosis (CSNN) on True Fir (Abies spp.). Fungal Biol. 2010, 114, 545–554. [Google Scholar] [CrossRef]
- Silva, A.C.; Henriques, J.; Diogo, E.; Ramos, A.P.; Bragança, H. First Report of Sydowia polyspora Causing Disease on Pinus pinea Shoots. For. Pathol. 2020, 50, e12570. [Google Scholar] [CrossRef]
- Pan, Y.; Ye, H.; Lu, J.; Chen, P.; Zhou, X.-D.; Qiao, M.; Yu, Z.-F. Isolation and Identification of Sydowia polyspora and Its Pathogenicity on Pinus yunnanensis in Southwestern China. J. Phytopathol. 2018, 166, 386–395. [Google Scholar] [CrossRef]
- Donaubauer, E. Distribution and Hosts of Scleroderris lagerbergii in Europe and North America. Eur. J. For. Pathol. 1972, 2, 6–11. [Google Scholar] [CrossRef]
- Santamaría, O.; Pajares, J.A.; Diez, J.J. First Report of Gremmeniella abietina on Pinus halepensis in Spain. Plant Pathol. 2003, 52, 425. [Google Scholar] [CrossRef]
- Middelhoven, W.J. The Yeast Flora of the Coast Redwood, Sequoia sempervirens. Folia Microbiol. 2003, 48, 361–362. [Google Scholar] [CrossRef] [PubMed]
- Pirttilä, A.M. Endophytic Bacteria in Tree Shoot Tissues and Their Effects on Host. In Endophytes of Forest Trees: Biology and Applications; Pirttilä, A.M., Frank, A.C., Eds.; Forestry Sciences; Springer International Publishing: Basel, Switzerland, 2018; pp. 177–190. ISBN 978-3-319-89833-9. [Google Scholar]
- Zhao, J.-H.; Bai, F.-Y.; Guo, L.-D.; Jia, J.-H. Rhodotorula pinicola Sp. Nov., a Basidiomycetous Yeast Species Isolated from Xylem of Pine Twigs. FEMS Yeast Res. 2002, 2, 159–163. [Google Scholar] [CrossRef] [PubMed][Green Version]
- Cadete, R.; Rocha Lopes, M.; Rosa, C. Yeasts Associated with Decomposing Plant Material and Rotting Wood. In Yeasts in Natural Ecosystems: Diversity; Springer International Publishing: Basel, Switzerland, 2017; pp. 265–292. ISBN 978-3-319-62682-6. [Google Scholar]
- Terhonen, E.; Keriö, S.; Sun, H.; Asiegbu, F.O. Endophytic Fungi of Norway Spruce Roots in Boreal Pristine Mire, Drained Peatland and Mineral Soil and Their Inhibitory Effect on Heterobasidion parviporum in Vitro. Fungal Ecol. 2014, 9, 17–26. [Google Scholar] [CrossRef]
- Courty, P.-E.; Franc, A.; Pierrat, J.-C.; Garbaye, J. Temporal Changes in the Ectomycorrhizal Community in Two Soil Horizons of a Temperate Oak Forest. Appl. Environ. Microbiol. 2008, 74, 5792–5801. [Google Scholar] [CrossRef]
- Pickles, B.J.; Genney, D.R.; Potts, J.M.; Lennon, J.J.; Anderson, I.C.; Alexander, I.J. Spatial and Temporal Ecology of Scots Pine Ectomycorrhizas. New Phytol. 2010, 186, 755–768. [Google Scholar] [CrossRef] [PubMed]
- Davey, M.L.; Heegaard, E.; Halvorsen, R.; Ohlson, M.; Kauserud, H. Seasonal Trends in the Biomass and Structure of Bryophyte-Associated Fungal Communities Explored by 454 Pyrosequencing. New Phytol. 2012, 195, 844–856. [Google Scholar] [CrossRef] [PubMed]
- Martín-Pinto, P.; Nanos, N.; Diez, J.J.; Pajares, J.A. Site and Seasonal Influences on the Fungal Community on Leaves and Stems of Pinus and Quercus Seedlings in Forest Nurseries. Sydowia 2004, 56, 243–257. [Google Scholar]
- Luchi, N.; Longa, C.M.O.; Danti, R.; Capretti, P.; Maresi, G. Diplodia sapinea: The Main Fungal Species Involved in the Colonization of Pine Shoots in Italy. For. Pathol. 2014, 44, 372–381. [Google Scholar] [CrossRef]
- Adomas, A.; Heller, G.; Olson, Å.; Osborne, J.; Karlsson, M.; Nahalkova, J.; Van Zyl, L.; Sederoff, R.; Stenlid, J.; Finlay, R.; et al. Comparative Analysis of Transcript Abundance in Pinus sylvestris after Challenge with a Saprotrophic, Pathogenic or Mutualistic Fungus. Tree Physiol. 2008, 28, 885–897. [Google Scholar] [CrossRef][Green Version]
- Mukrimin, M.; Kovalchuk, A.; Ghimire, R.P.; Kivimäenpää, M.; Sun, H.; Holopainen, J.K.; Asiegbu, F.O. Evaluation of Potential Genetic and Chemical Markers for Scots Pine Tolerance against Heterobasidion annosum Infection. Planta 2019, 250, 1881–1895. [Google Scholar] [CrossRef] [PubMed]
- Danielsson, M.; Lundén, K.; Elfstrand, M.; Hu, J.; Zhao, T.; Arnerup, J.; Ihrmark, K.; Swedjemark, G.; Borg-Karlson, A.-K.; Stenlid, J. Chemical and Transcriptional Responses of Norway Spruce Genotypes with Different Susceptibility to Heterobasidion spp. Infection. BMC Plant Biol. 2011, 11, 154. [Google Scholar] [CrossRef] [PubMed]
- Linnakoski, R.; Sugano, J.; Junttila, S.; Pulkkinen, P.; Asiegbu, F.O.; Forbes, K.M. Effects of Water Availability on a Forestry Pathosystem: Fungal Strain-Specific Variation in Disease Severity. Sci. Rep. 2017, 7, 13501. [Google Scholar] [CrossRef] [PubMed]
- Brookhouser, L.W. Infection of Austrian, Scots, and Ponderosa Pines by Diplodia pinea. Phytopathology 1971, 61, 409. [Google Scholar] [CrossRef]

| Sampling Time | June | June | September | September | |||||||||||||||||||||
|---|---|---|---|---|---|---|---|---|---|---|---|---|---|---|---|---|---|---|---|---|---|---|---|---|---|
| Growth year | 2017 | 2018 | 2017 | 2018 | |||||||||||||||||||||
| Disease class | 0 | 1 | 2 | 3 | 4 | 5 | 0 | 1 | 2 | 3 | 4 | 5 | 0 | 1 | 2 | 3 | 4 | 5 | 0 | 1 | 2 | 3 | 4 | 5 | * Total |
| No. Scots pine trees sampled in each disease class | 5 | 5 | 5 | 5 | 5 | 5 | 5 | 5 | 5 | 5 | 5 | 5 | 5 | 5 | 5 | 5 | 3 | 4 | 5 | 5 | 5 | 5 | 3 | 4 | 35 |
| No. of twigs sampled for HTS | 5 | 5 | 5 | 5 | 5 | 5 | 5 | 5 | 5 | 5 | 5 | 5 | 5 | 5 | 5 | 5 | 5 | 5 | 5 | 5 | 5 | 5 | 5 | 5 | 114 |
| Amplicon sequencing successful (HTS) | 2 | 3 | 5 | 2 | 4 | 1 | 5 | 5 | 5 | 5 | 5 | 5 | 4 | 3 | 4 | 5 | 2 | 4 | 5 | 5 | 5 | 5 | 3 | 3 | 95 |
| No. of twigs sampled for isolation | 10 | 10 | 10 | 10 | 10 | 10 | 10 | 10 | 10 | 10 | 10 | 10 | 10 | 10 | 10 | 10 | 6 | 8 | 10 | 10 | 10 | 10 | 6 | 8 | 228 |
| No. of segments sterilized | 47 | 49 | 51 | 50 | 43 | 55 | 56 | 78 | 72 | 90 | 77 | 72 | 54 | 51 | 55 | 40 | 23 | 34 | 58 | 74 | 63 | 69 | 43 | 54 | 1358 |
| No. of isolates | 55 | 48 | 55 | 51 | 42 | 60 | 44 | 71 | 69 | 79 | 66 | 58 | 86 | 60 | 72 | 50 | 38 | 40 | 80 | 71 | 63 | 78 | 46 | 53 | 1425 |
| Mean no. of isolates per shoot | 5.5 | 4.8 | 5.3 | 5.1 | 4.2 | 6 | 4.4 | 7.1 | 6.9 | 7.9 | 6.6 | 5.8 | 8.6 | 6.9 | 7.2 | 5 | 4.7 | 5 | 8 | 7.1 | 6.3 | 7.8 | 7.7 | 6.3 | 6.83 |
| Mean no. of taxa isolated | 3.8 | 1.8 | 2.6 | 2.2 | 2.8 | 3.2 | 5.8 | 2.4 | 3.8 | 2.6 | 2.7 | 3 | 2.2 | 2.8 | 3 | 3.8 | 2.6 | 3.2 | 4.4 | 4.2 | 3.8 | 4.2 | 5.3 | 4 | - |
| Taxon | Author | Frequency (No. of Isolates/Total No. of Isolations (%)) | GenBank Accession Number (This Study) |
|---|---|---|---|
| Yeasts | 1.61 | not sequenced | |
| Fungus spp. ascomycetous | 1.40 | not sequenced | |
| Penicillium spp. | 0.14 | not sequenced | |
| Alternaria alternata | (Fr.) Keissl. | 0.63 | MT790311 |
| Biscogniauxia mediterranea | (De Not.) Kuntze | 0.14 | MT790312 |
| Biscogniauxia nummularia | (Bull.) Kuntze | 0.35 | MT790313 |
| Botrytis cinerea | Pers. | 0.14 | MT790314 |
| Desmazierella acicola | Lib. | 1.54 | MT790315 |
| Diaporthe sp. | 0.91 | MT790316 | |
| Epicoccum nigrum | Link | 0.49 | MT790317 |
| Hypoxylon fragiforme | (Pers.) J. Kickx f. | 0.14 | MT790318 |
| Jugulospora rotula | (Cooke) N. Lundq. | 0.07 | MT790319 |
| Microsphaeropsis olivacea | (Bonord.) Höhn. | 6.95 | MT790320 |
| Nemania serpens | (Pers.) Gray | 0.14 | MT790321 |
| Pezicula eucrita | (P. Karst.) P. Karst. | 0.21 | MW365343 |
| Pezizomycetes sp. | 0.14 | strain died | |
| Phacidium lacerum | Fr. | 0.07 | not cultivated |
| Preussia funiculata | (Preuss) Fuckel | 0.07 | MT790322 |
| Pseudocamarosporium brabeji | Marinc, M.J. Wingf. & Crous) Crous | 0.07 | MT790323 |
| Pyronema domesticum | (Sowerby) Sacc. | 0.21 | MT790324 |
| Rosellinia sp. | 0.21 | MT790325 | |
| Sordaria fimicola | (Roberge ex Desm.) Ces. & De Not. | 0.35 | not cultivated |
| Sphaeropsis sapinea | (Fr.) Dyko & B. Sutton | 59.44 | MT790326 andMT790327 |
| Sydowia polyspora | (Bref. & Tavel) E. Müll. | 18.53 | MT790328 |
| Truncatella conorum-piceae | (Tubeuf) Steyaert | 7.86 | MT790329 |
| Therrya fuckelii | (Rehm) Kujala | 0.07 | MT790330 |
Publisher’s Note: MDPI stays neutral with regard to jurisdictional claims in published maps and institutional affiliations. |
© 2021 by the authors. Licensee MDPI, Basel, Switzerland. This article is an open access article distributed under the terms and conditions of the Creative Commons Attribution (CC BY) license (https://creativecommons.org/licenses/by/4.0/).
Share and Cite
Blumenstein, K.; Bußkamp, J.; Langer, G.J.; Langer, E.J.; Terhonen, E. The Diplodia Tip Blight Pathogen Sphaeropsis sapinea Is the Most Common Fungus in Scots Pines’ Mycobiome, Irrespective of Health Status—A Case Study from Germany. J. Fungi 2021, 7, 607. https://doi.org/10.3390/jof7080607
Blumenstein K, Bußkamp J, Langer GJ, Langer EJ, Terhonen E. The Diplodia Tip Blight Pathogen Sphaeropsis sapinea Is the Most Common Fungus in Scots Pines’ Mycobiome, Irrespective of Health Status—A Case Study from Germany. Journal of Fungi. 2021; 7(8):607. https://doi.org/10.3390/jof7080607
Chicago/Turabian StyleBlumenstein, Kathrin, Johanna Bußkamp, Gitta Jutta Langer, Ewald Johannes Langer, and Eeva Terhonen. 2021. "The Diplodia Tip Blight Pathogen Sphaeropsis sapinea Is the Most Common Fungus in Scots Pines’ Mycobiome, Irrespective of Health Status—A Case Study from Germany" Journal of Fungi 7, no. 8: 607. https://doi.org/10.3390/jof7080607
APA StyleBlumenstein, K., Bußkamp, J., Langer, G. J., Langer, E. J., & Terhonen, E. (2021). The Diplodia Tip Blight Pathogen Sphaeropsis sapinea Is the Most Common Fungus in Scots Pines’ Mycobiome, Irrespective of Health Status—A Case Study from Germany. Journal of Fungi, 7(8), 607. https://doi.org/10.3390/jof7080607

